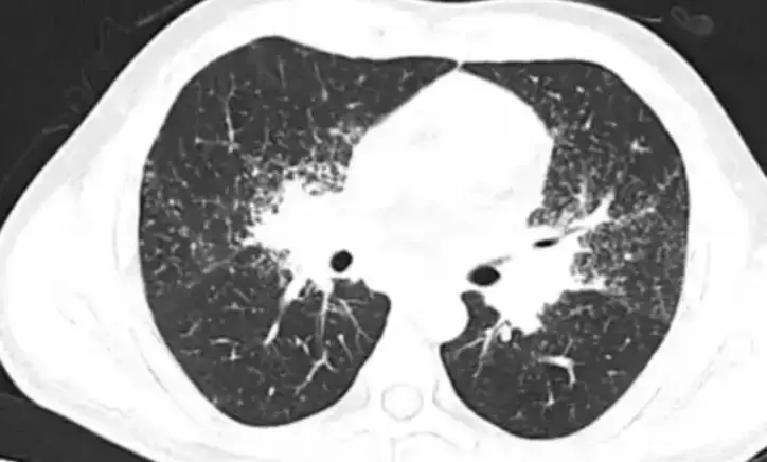

55岁体检刚查出右肺节,冬梅阿姨瞬间慌了神:胸闷气短越来越重,是不是癌已经扩散了? 体检报告上那几个字像炸雷一样砸下来,很多人一看到“肺结节”就脑补最坏结果,夜不能寐,甚至直接冲去医院嚷着要切掉。现实却残酷反差:最新体检大数据显示,2024年肺结节检出率已飙到59.3%,比前一年涨了不少,可其中90%以上是良性,真正恶变的比例极低。 关键在于,结节本身不等于癌,它只是影像学发现的一个小信号。多数人平时没症状,纯靠高分辨率CT才逮住这些过去漏掉的微小团块。设备越先进,发现率越高,但别把数量当成危险信号。 真正拉响警报的,是身上同时冒出几种表现。咳嗽拖过8周,反反复复停不下来,尤其是清晨夜里加剧,这往往提示结节周边有炎症或压迫。很多人觉得年纪大了咳两声正常,结果一拖再拖,错过最佳排查窗口。 胸闷气短更不能不当回事。以前轻松爬楼,现在一层就喘得停步,活动耐量直线下降,结合结节存在,就得警惕肺功能真在下滑。别总甩锅给“岁数大”,这可能是结节影响供氧的红灯。 痰里反复带血丝,颜色暗红或鲜红,千万别当成上火咽下去。这信号最尖锐,对有结节的人来说,支气管可能已被侵犯,早期查清楚远比晚期后悔强。 还有不明原因的消瘦乏力、低烧盗汗,三个月体重掉超5%,下午晚上总烧到37.5℃左右,衣服夜里汗湿透。这种全身消耗状态,身体像在打仗,慢性感染或恶变都得高度怀疑。 数据上普通人群肺结节恶性风险才4-5%左右,高危因素叠加才推高概率:长期吸烟、50岁以上、家族肺癌史、粉尘油烟长期暴露。这些人结节一旦有动静,医生才会格外盯紧。 管理上别走极端。多数节只需6-12个月复查CT,稳定了就能拉长间隔。直径超8mm、边缘毛刺、磨玻璃成分多的,才考虑增强CT或活检,早分清性质。盲目切除反而伤肺功能,得不偿失。 现在最该做的,是戒掉烟酒、躲开二手烟和油烟,规律生活控好三高,提升免疫。任何“神药偏方”都别信,没证据能吃掉结节,只会耽误正经路子。 肺结节像身体发出的预警,不是判决书。科学随访+主动避险,大部分人能安心共存,真正把风险掐在萌芽。早发现的价值,就在于给选择留足空间,而不是制造恐慌。